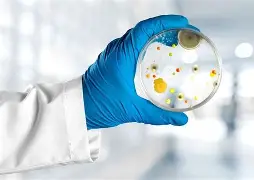

服务范围
- I类(煤矿)防爆设备ATEX认证
- II类(除煤矿外气体环境)防爆设备ATEX认证
- III类(粉尘环境)防爆设备ATEX认证
- 电气与非电气防爆设备
- 保护系统与安全装置
检测标准
- 2014/34/EU ATEX指令
- EN 60079 系列爆炸性环境标准
- EN ISO 80079 系列非电气防爆标准
- ISO/IEC 80079-34 质量体系要求
检测项目
- 产品类别与模块选择评估
- 技术文件(TCF)编制与审核
- 型式试验协调与跟踪
- 工厂质量体系审核辅导
- CE标志使用指导
- EC符合性声明编制
测试周期
3-6个月(根据产品复杂度和公告机构排期)
相关资质
我们与多家欧盟公告机构(Notified Body)建立战略合作,可为客户推荐最适合产品类型的发证通道。技术团队由具备国际防爆认证经验的工程师组成,熟悉ATEX认证的技术要求与流程规范。所有辅导项目均建立中英双语技术档案,确保与公告机构沟通无障碍。
服务背景
ATEX认证是欧盟对防爆设备的强制性准入要求,无ATEX证书的产品不得在欧盟市场销售。然而,中国企业在申请ATEX时常面临三大障碍:一是对指令和标准理解不深,技术文件屡被退回;二是不熟悉公告机构的运作模式,沟通效率低下;三是缺乏工厂审核经验,因体系细节不达标而延误发证。随着欧盟市场监管力度加大,这些问题可能导致更大的合规风险。专业的ATEX认证服务,已成为中国企业出口欧盟的必然选择。
我们的优势
汇策集团综合检测提供“中西合璧”的ATEX认证服务。我们的团队既懂中国企业的研发和生产习惯,也深谙欧盟公告机构的审核逻辑。在技术文件准备阶段,我们严格按照ATEX要求编制英文版图纸、说明书和风险评估报告;在测试阶段,我们协助客户与国外实验室高效沟通,第一时间解决技术疑问;在工厂审核阶段,我们派专家现场模拟审核,帮助企业查漏补缺。我们已成功协助数十家中国企业获得ATEX证书,覆盖隔爆电机、本安仪表、防爆灯具等多个品类。选择汇策集团综合检测,让您的产品稳健迈入欧盟市场。
 alt="微信二维码">
alt="微信二维码">